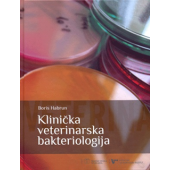
Klinička veterinarska bakteriologija

Virusne bolesti životinja
Autor Slavko Cvetnić
Jezik hrvatski
Broj strana 492
Uvez tvrdi
Godina izdavanja 2005.
Izdavač Školska knjiga
Details
Iz potrebe da se studentima veterine pruži učevno štivo, a u nedostatku takva udžbenika, napisao sam 1975. godine udžbenik Virusne bolesti domaćih životinja, u nakladi Izdavačkog poduzeća Liber u Zagrebu, zbog povoljnog prijama na koji je udžbenik naišao, tekst sam proširio i dopunio opisom novih bolesti, i već 1977. godine isti je nakladnik tiskao Virusne bolesti životinja. I ta je knjiga, s ponešto teksta što nije namijenjen samo studentima, ubrzo rasprodana.
Iskustva s tim dvjema knjigama i prijam na koji su naišle bili ,su izazovom i poticajem da se cjelokupna problematika zahvati još cjelovitije i svrhovitije. Plod toga je ova knjiga. Osnovna želja pri njezinu pripremanju bila je da se čitatelju pruži prva i što obuhvatnija osnovna informacija o bolestima i infekcijama životinja uzrokovanima virusima. Često samo napomenuti podaci mogu biti putokazom za daljnje poniranje u bit pojedine bolesti ili infekcije.
Čini se da je raspored opisanih bolesti upravo ovakav kakav je u knjizi najprikladniji. Bolesti su svrstane po osnovnim kliničkim znakovima kojima se očituju. Izuzetak su bolesti riba koje, svrstane u zasebnu skupinu, čine logičniju cjelinu.
Questions (0)
Komentari